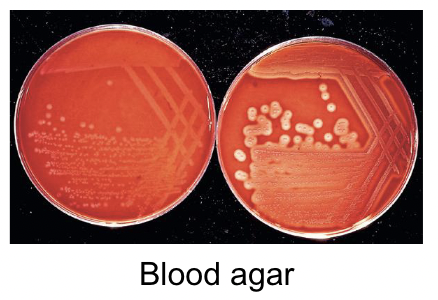
<p>Blood agar </p><p>Small greyish colonies </p><p>Weak beta hemolytic </p>

1/9
Looks like no tags are added yet.
Name | Mastery | Learn | Test | Matching | Spaced |
|---|
No study sessions yet.
What would you see under microscope
Short gram positive rods/coccobacilli

What agent causes listeriosis in ruminants
Listeria monocytogenes
What does l. monocytogenes cause
Neural listeriosis, obrtions, septicemia, stiff necks,

How is it transmitted
Contact with contaminated feeds, soils, equipment and through teats
Role of internalins
Mediate adherence and invasion of non phagocytic cells → facilitates crossing barriers
Role of listeriolysin
After bacteria is engulfed in host cell, they are trapped in a membrane bound comprtment called a phagosome
Listeriolysin allows bacterium to create pores, breaking into host cell cytoplasm where it can replicate
Samples
Samples from brainstem tissue (post mortem), CSF, placenta, fetal tissues, liver, spleen
Culture
Blood agar
Small greyish colonies
Weak beta hemolytic
Biochemical features
Catalase positive
Camp test positive
What other test can you use
Immunofluorescence using monoclonal Ab